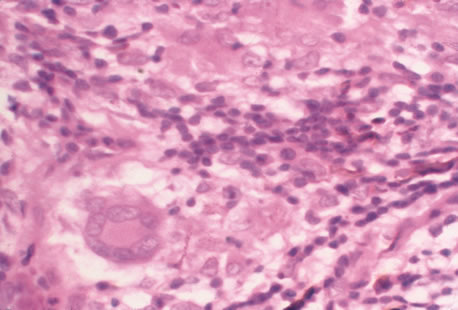

HERPES SIMPLEX VIRUS
The herpes simplex virus (HSV) is a common cause of ocular, perioral, and genital infection in humans. The viral particle consists of a core of double-stranded DNA surrounded by a protein capsid and lipid envelope. After the primary infection, HSV survives in latent form inside sensory nerve ganglia and may reactivate at any time producing recurrent disease. HSV type 1 accounts for the majority of herpes labialis and ocular herpetic infections. HSV type 2 causes genital herpes infections.1
HSV has a worldwide distribution, and humans are the only known reservoir. HSV keratitis is a serious cause of blindness, and is second in incidence only to trachoma in terms of corneal-related causes of blindness. Transmission requires close personal contact. HSV type 1 is transmitted primarily by oral secretions and HSV type 2 by genital secretions. Primary exposure to HSV type 1 commonly occurs in childhood. By puberty, 60% to 85% of the population has serologic evidence of HSV type 1 infection. In contrast, the incidence of HSV type 2 cases does not begin to increase until approximately 14 years of age and ranges from 3% in sexually inactive populations to 70% in prostitutes.2
The incubation period for HSV is from 2 to 14 days. Primary infection with HSV type 1 is often asymptomatic but may produce oral, eye, or skin lesions (Fig. 1). In children younger than age 5, a painful gingivostomatitis or pharyngitis with fever and cervical adenopathy is the most common presentation. HSV type 2 infections usually involve the glans penis and penile shaft in men, and the vulva, perineum, buttocks, cervix, and vagina in women.1 Fever, malaise, anorexia, and tender inguinal adenopathy may accompany the typical vesicular skin eruption. The ulcerated lesions are exquisitely tender and may persist for several weeks before healing.
|
Congenital HSV infection is recognized at birth by jaundice, hepatosplenomegaly, central nervous system abnormalities, bleeding diatheses, microcephaly, seizure disorders, fever, chorioretinitis, and skin vesicles. It must be differentiated from similar syndromes caused by rubella, toxoplasmosis, and cytomegalovirus. Neonatal infection may be acquired in passing through the infected birth canal or by retrograde spread of the infection into the uterine cavity.
Less common presentations of HSV infection include primary infections of the skin of the fingers (whitlows). These are caused by HSV type 1 in medical and dental personnel exposed to oral secretions. In the general community this lesion is caused by HSV type 2 infection. HSV type 1 may also cause a skin infection that mimics herpes zoster, although the dermatomal distribution is not usually maintained and the pain is less severe. On rare occasions, herpes simplex can cause a necrotizing hemorrhagic encephalitis of the temporal lobes marked by rapid deterioration to coma and death.
Reactivation of HSV may be precipitated by fever, trauma, menstruation, emotional stress, or systemic illness. Recurrent episodes of HSV type 1 and type 2 are generally preceded by several hours of burning, itching, and tingling before the skin vesicles appear. Systemic symptoms tend to be mild or absent, with the exception of recurrent adenopathy. The lesions appear similar to the primary infection and are frequently painful. The most frequent regional recurrences of HSV type 1 are on the vermilion border of the outer lip (herpes labialis) and in the eye (Fig. 2). Recurrences of HSV type 2 characteristically produce lesions on the penile shaft and glans in the male and on the labia and perineum in the female. Headache and aseptic meningitis are occasionally associated with a genital recurrence. Further recurrences may be seen at monthly or yearly intervals.
|
In primary ocular HSV infections, a severe follicular conjunctivitis with regional adenopathy is present. Vesicles may appear on the eyelid skin or lid margin, producing blepharitis (Fig. 3). Corneal involvement initially takes the form of a superficial punctate keratitis, which may progress to dendritic or geographic ulceration. Stromal infiltrates and uveitis are less common and relatively mild in primary disease. In uncomplicated cases, lesions usually heal completely in 2 to 3 weeks without scarring. Most cases of ocular HSV are recurrences. Recrudescent ocular herpes may take the form of dendritic or geographic ulcers, recurrent erosions, interstitial or disciform stromal keratitis, and anterior uveitis.3 HSV may also be an agent of retinitis and acute retinal necrosis (Fig. 4).
|
|
Clinical diagnosis of HSV infection can be made when the characteristic vesicular lesions are present. The diagnosis can be confirmed by isolation of the virus in tissue culture when necessary. Scraping the base of the lesions and Wright's, Giemsa, or Papanicolaou's stains will demonstrate the characteristic giant cells or intranuclear inclusions of herpesvirus infection.
Most infections with HSV are mild or asymptomatic and require no specific treatment; however, antiviral therapy can be life saving in cases of neonatal herpes, disseminated infections, and herpes encephalitis. Famciclovir and valacyclovir effective in reducing the pain, healing time, and duration of viral shedding in patients with first episode genital herpes and significantly shortens the clinical and virologic course in recurrent episodes. Immunocompromised patients with chronic progressive oral herpes have also demonstrated improved healing times and decreased viral shedding when treated with oral antivirals.4 Intravenous acyclovir is the drug of choice in the treatment of neonatal herpes infections and herpes encephalitis.
The corneal scarring caused by recurrent infection with HSV may be visually disabling and may require corneal transplantation. Over the course of the last decade, the Herpetic Eye Disease Study Group (HEDS) examined the short-term and long-term effects of oral acyclovir and topical steroids on epithelial keratitis, stromal keratitis and iritis. Long-term oral acyclovir was shown to reduce the rate of recurrent HSV epithelial keratitis and stromal keratitis, especially in those who have had multiple prior episodes of stromal keratitis.5,6 Topical steroids are beneficial in preventing progression of stromal inflammation and shortening duration of stromal keratitis. Topical steroids should be given in conjunction with topical Viroptic (King Pharmaceuticals, Bristol, TN) in those with stromal disease or disciform keratitis, but steroids should be avoided in those with epithelial disease. The HEDS trial showed a beneficial trend in the treatment of anterior herpetic uveitis with oral acyclovir, but the trend failed to reach statistical significance.7 Nevertheless, practitioners routinely use oral acyclovir in addition to topical steroids plus a cycloplegic for herpetic-related uveitis. Topical steroids are often difficult to discontinue and many patients require low-dose therapy for an indefinite amount of time.
VARICELLA AND HERPES ZOSTER
Varicella zoster virus (VZV) is an enveloped DNA-containing virus that is morphologically indistinguishable from other members of the herpesvirus family. Varicella is the primary infection. It usually occurs in children and is characterized by a generalized vesicular rash (chickenpox) with insignificant systemic manifestations. Herpes zoster is a reactivation of VZV in adults resulting in a dermatomal eruption of vesicles (shingles) which is usually accompanied by pain in the affected nerve distribution.8
Varicella occurs most commonly in the late winter and early spring. The highest attack rate is in the 2- to 8-year-old group. The infection is highly contagious and is presumably transmitted through direct person-to-person contact or by respiratory droplets. Approximately 96% of susceptible children will develop the disease within 1 month of exposure to the index case. Herpes zoster infections are seen in patients of all ages and occur with equal frequency throughout the year. Almost all infections occur with a history of prior exposure and are believed to be the result of reactivation of latent virus. The incidence of herpes zoster increases with age and is greater in immunocompromised persons.
Varicella usually begins 2 weeks after exposure to a preexisting case. There may be a short prodromal period before the rash develops marked by fever, headache, malaise, and lethargy. The exanthem usually starts on the scalp and the trunk and first appears as erythematous macules that progress to papules and then vesiculate. The lesions remain infectious until they crust over, which occurs in approximately 1 week. Successive crops of new lesions appear so that all stages and sizes of lesions may be present at the same time. Mucosal surfaces in the mouth and conjunctiva may be involved as well. The active course of an uncomplicated case is usually over in 7 to 10 days after which the virus remains in a latent state within the dorsal root ganglion of the sensory nerves.
In the majority of cases of herpes zoster, pain and paresthesias precede the skin eruption by several days. The skin lesions morphologically resemble those of varicella; however, they tend to be larger and more bullous. The lesions conform to dermatomal distributions and do not cross the midline. The thoracic nerves are most frequently involved followed by the trigeminal and cervical nerves.
Herpes zoster occurs more commonly in patients with impaired immunity such as those with neoplastic disease, particularly lymphoproliferative disease, or human immunodeficiency virus (HIV).9 In uncomplicated herpes zoster the majority of patients younger than 60 will have complete resolution of their pain and skin lesions within 4 weeks. The persistence of pain beyond this point (postherpetic neuraglia) is more common in the elderly population.
Most ophthalmic involvement by varicella is mild.10 Pocks on the eyelids and a nonspecific papillary conjunctivitis with a watery discharge are common findings. Foci of inflammatory cells may appear on the bulbar conjunctiva, limbus, or peripheral cornea either during the acute illness or weeks to months afterward. These pock-like lesions often ulcerate and are associated with conjunctival hemorrhage and a mucopurulent discharge containing primarily neutrophils. When on the cornea, they may leave faint superficial scars with neovascularization. Occasionally, varicella can cause a punctate, dendritic, geographic, or disciform keratitis associated with a mild to moderate iridocyclitis. Unusual ocular complications of varicella include necrosis of the eyelids, interstitial keratitis, corneal melting, cataract, and optic neuritis. Congenital infection may result in microphthalmia, cataract, chorioretinitis, microcephaly, deafness, and cardiac abnormalities.
Involvement by VZV of the first division of the trigeminal nerve is referred to as herpes zoster ophthalmicus regardless of whether the eye is inflamed (Fig. 5). Eighty-five percent of patients with cutaneous eruptions on the side of the tip or midportion of the nose (Hutchinson's sign) will have ocular involvement. Varicella zoster virus can cause blepharitis, canaliculitis, episcleritis, scleritis, conjunctivitis, keratitis, iridocyclitis, uveitis, retinal vasculitis, retinitis, choroiditis, and optic neuritis. Cataracts and glaucoma are late complications related to the uveitis and long-term use of topical corticosteroid therapy.
|
Corneal complications occur in the majority of patients with herpes zoster ophthalmicus. A punctate epithelial keratopathy with pseudodendrite formation is the earliest and most common lesion that occurs. Stromal infiltrates, disciform reactions, and rarely interstitial keratitis are also observed. Scarring and contracture of the lid margin often results in trichiasis, distichiasis, entropion, or ectropion. Corneal sensation is reduced, and neurotrophic ulceration, corneal melting, or perforation may ensue. Extraocular muscle involvement with facial paresis has been observed.11
The acute retinal necrosis (ARN) syndrome is most often caused by the herpes zoster virus, although occasionally it may be a result of herpes simplex infection.12 It is typically described in healthy patients although association with immunosuppressed patients has also been described. Granular, nonhemorrhagic areas of retinal necrosis may be observed in the fundus, often rapidly coalescing with resulting blindness often caused by retinal detachment. There is often an associated vasculitis and vitritis. In immunocompromised patients VZV or HSV retinitis may also take the pattern of progressive outer retinal necrosis (PORN) (Fig. 6). PORN differs from ARN in that the former is multifocal, localized to the outer retina, and is less often associated with vasculitis and vitritis.
|
Diagnosis of varicella is usually not difficult, given the frequently obtainable history of exposure to a preexisting case and the characteristic rash. Serologic confirmation can be obtained by demonstrating increasing anti-VZV antibody titers. Multinucleated giant cells and eosinophilic intranuclear inclusions can be demonstrated by Papanicolaou's or other stains of smears from acute skin lesions.
The clinical diagnosis of herpes zoster can be made in the presence of the characteristic vesicular lesions in a dermatomal distribution. Scrapings of the lesions demonstrate giant cells and intracellular inclusions. It is important to note that although most patients with herpes zoster are otherwise healthy, the possibility of an underlying systemic illness should be considered if the patient is young (i.e., younger than 50 years old) or the history suggests other systemic problems.
The treatment of varicella is primarily supportive, consisting of analgesia, antipyretics, antipruritics, and good skin hygiene to prevent secondary infection. The use of aspirin in children is to be avoided in view of the belief that it may predispose to Reye's syndrome following varicella. Most eye disease is mild and self-limited and does not require treatment.
Oral acyclovir (Zovirax) given five times daily early in the course of zoster infection has been shown to reduce the duration of viral shedding and the severity of acute pain. The greatest benefit is seen when medication is begun within 72 hours of onset of skin lesions. Two newer antiviral agents available for the treatment of herpes zoster are valacyclovir (Valtrex) and famcyclovir (Famvir). These agents have the advantage of a simpler dosing regimen, three times daily rather than five times daily with acyclovir, and a more favorable pharmacokinetic profile.13 It is thought that famcyclovir may also help speed resolution of postherpetic neuralgia. Valacyclvoir and famcyclovir are now preferred to acyclovir as first-line therapy for the treatment of zoster. They are well-tolerated drugs with few systemic side effects other than a requirement for reduced dosing in patients with renal failure. Oral corticosteroids also seem to have a beneficial effect in reducing acute pain and speeding cutaneous healing. They have not been shown to have an effect on postherpetic neuralgia.
Topical corticosteroids and cycloplegics are commonly used to treat the inflammation associated with herpes zoster ophthalmicus.10 Tear supplements, bandage contact lenses, surgical correction of lid abnormalities, and tarsorrhaphy may be necessary to promote the healing of epithelial defects. Vision-threatening pathologic processes such as chorioretinitis and optic neuritis should be treated aggressively with intravenous acyclovir and high doses of prednisone.
Treatment of postherpetic neuralgia is often disappointing. Routine analgesic drugs are generally ineffective. Cimetidine, colchicine, phenothiazines, and tricyclic antidepressants have been used with some success. Capsaicin cream and lidocaine patches may also be applied for local relief. The pain tends to slowly diminish and disappear over the course of 1 to 2 years but may be prolonged, especially in elderly patients. For those with severe intractable pain, intrathecal injection of methylprednisolone acetate once weekly for 4 weeks has recently been shown to provide relief.14
CYTOMEGALOVIRUS INFECTION
Cytomegalovirus (CMV) is a herpes virus responsible for severe congenital malformations, a mononucleosis syndrome in young adults, and disseminated lesions in the immunosuppressed, especially retinal infection and pneumonia in patients with acquired immunodeficiency syndrome (AIDS). Patients with AIDS with CD4 counts between 50 to 100 cells per microliter are particularly susceptible to CMV retinitis. If the retinitis is untreated the prognosis is very poor often resulting in full-thickness retinal necrosis and blindness. Despite treatment, CMV retinitis often recurs in up to 50% of cases.15
In the United States, 20% of people are seropositive for CMV by age 20. Approximately 1% of infections are congenital and 5% perinatal. Anti-CMV immunoglobulin (Ig) G is present in greater frequency in homosexual men, on the order of 80% to 90%. The virus may be transmitted via blood, cervical secretions, semen, and breast milk and as an intrauterine infection. Serologic testing for CMV is not routinely performed because of this frequent exposure in the general population.
Approximately 10% of congenitally infected newborns have permanent sequelae. The full syndrome is manifest as hepatosplenomegaly with hepatitis and cirrhosis, maculopapular rash, purpura, hemolytic anemia, pneumonia, microcephaly, microgyria, encephalitis, chorioretinitis, pathologic bone fractures, and growth retardation. Otherwise asymptomatic children may develop late sensorineural hearing loss or mental retardation.
In normal older children and adults, the most common manifestation is an atypical mononucleosis, comprising fever and lymphocytosis with atypical lymphocytes. Lymphadenopathy and pharyngitis may be present, and rubelliform rashes occur. Heterophil antibodies are negative.
In the immunocompromised, especially organ transplant recipients and patients with AIDS, CMV commonly is responsible for serious clinical syndromes. It causes an interstitial pneumonia, resulting in dyspnea and dry cough, with interstitial infiltrates on the roentgenogram. Subacute encephalitis, enterocolitis, adrenalitis, and adrenal necrosis may be noted.
CMV retinitis is common in patients with AIDS. Perivascular granular white or yellowish infiltrates with hemorrhage are typical (Fig. 7). Minimal vitritis or anterior uveitis may be present. The posterior pole, including optic nerve, or peripheral retina may be involved. Optic neuritis may be retrobulbar. Resolution of retinal lesions reveals local retinal atrophy and pigment dispersion. Iridocyclitis may occur secondary to infection of ciliary processes. CMV retinitis in patients with AIDS is considered a poor prognostic sign in terms of life expectancy. Congenital CMV infection may also cause retinitis, as well as anterior uveitis, cataract, and optic atrophy. New foci of retinochoroiditis can develop in later years of congenital infection, and such infants require periodic reexamination as long as virus is shed in the urine.
|
In the immunocompromised patient, other pathogens must be excluded, even in the presence of positive CMV cultures or serology. Tissue culture methods may take as long as 4 weeks. IgM antibody develops in primary infection and then disappears over 6 to 9 months, but it may reappear with reactivation of infection. The IgM test has unfortunately low specificity and sensitivity in infants and is less helpful than urine culture obtained at birth or in the first weeks of life.
Any cell type may be infected, appearing larger than normal (cytomegalic) and demonstrating eosinophilic intranuclear “owl's eye” and smaller intracytoplasmic viral inclusion bodies, which are better seen with Giemsa or Papanicolaou's stains (Fig. 8). Histologic examination of tissue specimens, including bronchoalveolar lavage fluid and urine, may be useful for diagnosis.
|
Gancyclovir, or dihydroxypropoxymethyl guanine (DHPG), prevents DNA synthesis in infected cells. It is recommended for consideration in immunocompromised patients with retinitis, pneumonitis, enterocolitis, encephalitis; in infants with severe congenital or acquired disease; and in otherwise healthy patients with acute severe primary cytomegalovirus infection. It is effective in treatment of various CMV lesions, resulting in clinical stabilization or improvement. However, relapse almost always occurs when the drug is discontinued. An exception to this rule has been noted of late in patients who sustain elevated CD4 counts through the aid of highly active antiretroviral therapy (HAART).16 HAART has dramatically increased the life expectancy of patients with AIDS with low CD4 counts, and it has also been shown to improve the outcome of patients with CMV retinitis.17 Gancyclovir is limited to intravenous use, and neutropenia occurs in approximately 20% of patients. The newer agent valgancyclovir (Valcyte; Roche, Basel, Switzerland) is an oral formulation that is considered more efficacious than its original intravenous counterpart. It is being used for induction as well as maintenance therapy. Zidovudine, a reverse transcriptase inhibitor often used in the treatment of HIV, also results in neutropenia and should not be used in association with gancyclovir.18
Intravenous foscarnet, cidofovir and fomivirsen are other anticytomegaloviral agents that are currently available.19,20 The primary toxicity of foscarnet and cidofovir is renal and requires strict monitoring of blood, urea, and nitrogen (BUN) and creatinine levels during treatment. After high-dose induction therapy, most patients require life-long maintenance therapy for all anticytomegaloviral agents. In those who cannot tolerate the systemic side effects associated with intravenous therapy, intravitreal injection or intravitreal implantation of gancyclovir is a consideration.21
ACQUIRED IMMUNODEFICIENCY SYNDROME
AIDS is a debilitating and fatal disease caused by HIV, characterized by T-cell lymphocytopenia, and development of secondary infections and tumors. CMV retinitis and other ocular manifestations of HIV-related disease are common.
For purposes of reporting and surveillance, the Centers for Disease Control (CDC) defines AIDS in terms of specific indicator diseases and laboratory evidence of HIV infection.22 In general, a case of AIDS is a reliably diagnosed opportunistic disease at least moderately indicative of underlying cellular immunodeficiency and with no other known cause of underlying cellular immunodeficiency or reduced resistance reported to be associated with an opportunistic disease, including secondary immunodeficiencies associated with immunosuppressive therapy, lymphoreticular malignancy, or starvation.
According to the CDC, as of the year 2000 approximately 800,000 people currently living in the United States have been infected with HIV, with approximately 40,000 newly diagnosed cases per year. Worldwide incidence of HIV infection is a much more menacing burden because more than 30 million people have been reportedly infected with the virus. The majority of these individuals are African American men, but during the last decade women have represented increasingly larger percentages of those afflicted. Homosexual intercourse is still the most common route of infection. However transmission of the virus is now more common in heterosexual sex, as well as through the sharing of contaminated needles in intravenous drug users. The mid to late 1990s showed a decline in the number of AIDS-related deaths as more potent antiretroviral medication became available. More recently there has been a leveling off in terms of the number of AIDS-related fatalities. Some experts postulate that as resistance begins to develop among patients on the newer, more potent drug regimens, there will again be a resurgence of deaths because of AIDS.23
Transplacental transmission from an infected mother is estimated to occur in 50% of cases. Breast milk may be a source of infection. There is currently no evidence for vector-borne transmission or infection via casual household contacts. The health care worker's risk for infection via needle stick is approximately 1 in 1000 punctures. The virus is very sensitive to heat, lipid solvents, and common antiseptics.
HIV was previously known as human, T-cell lymphotropic virus type 3 (HTLV-III) and lymphadenopathy-associated virus (LAV). There are two known types of virus: HIV type 1, which causes AIDS, and HIV type 2, the disease spectrum of which is uncertain. HIV type 2 has been found in some African cases of AIDS. HIV is a retrovirus, meaning it contains a reverse transcriptase enzyme that produces a double-stranded DNA copy (cDNA) from the virus RNA genome (Fig. 9).24 HIV infection involves attachment of viral envelope glycoprotein to the CD4 molecule present on T-helper (T4, OKT4, or CD4+) cell surfaces. The virus then fuses with the cell membrane, enters cytoplasm, loses its envelope, and reverse transcription of RNA to DNA occurs. Viral DNA becomes integrated into host cell DNA as latent provirus, in which state it may go unrecognized by the immune system. The proviral DNA can then be transcribed and translated, producing viral proteins and viral genome RNA, which assemble and bud through the host cell plasma membrane as new virions. Antigenic stimulation of lymphocyte activity appears to be important in conversion from latency to progressive infection.
|
HIV infection results in depletion of T4 cells, which are central to various forms of immune responsiveness. Risk of developing AIDS is inversely related to the absolute T4 cell count. Antigen-responsive T cells become selectively depleted or functionally impaired early in the course of AIDS. There is diminished helper function for B-cell responses, depressed cytotoxic and natural killer cell responsiveness, decreased blast transformation, and decreased lymphokine production. Infected patients' B-lymphocytes spontaneously produce immunoglobulin, resulting in hypergammaglobulinemia, but are unable to produce specific antibody in response to new infections. Anergy is common. HIV also infects other cells that express the CD4 antigen, such as monocytes and macrophages, but is not cytopathic in these cells. HIV has been identified in brain capillary endothelium, oligodendrocytes, astrocytes, lymph node dendritic cells, Langerhans' cells, intestinal mucosa, myocardium, tears, corneal epithelium, aqueous, vitreous, and retina.
Clinical manifestations of HIV are protean. Seropositive persons may be asymptomatic. Various acute HIV infection syndromes have been described. An acute mononucleosis-like syndrome, with fever, malaise, rash, lymphadenopathy, pharyngitis, myalgias, and arthralgias, has been noted after recent HIV exposure. Acute neurologic manifestations resembling aseptic meningitis, encephalitis, or focal lesions may be seen.25 AIDS-related complex is a somewhat ambiguous term encompassing features such as chronic fever, night sweats, weight loss, fatigue, generalized lymphadenopathy, chronic diarrhea, and laboratory abnormalities. AIDS-related complex implies an intermediate stage in the spectrum of HIV disease.
CDC-defined indicator diseases include HIV encephalopathy, HIV wasting syndrome, CMV disease not involving liver, spleen or lymph nodes (26), progressive multifocal leukoencephalopathy, recurrent Salmonella septicemia, multiple or recurrent serious bacterial infections in children, extrapulmonary myobacterial infection, disseminated histoplasmosis, disseminated coccidioidomycosis, chronic isosporiasis, lymphoid interstitial pneumonia or pulmonary lymphoid hyperplasia in children, primary brain lymphoma, and various non-T–cell non-Hodgkin's lymphomas. Less specifically associated with HIV infection are manifestations of papillomavirus, molluscum contagiosum, VZV, Epstein-Barr virus, hepatitis B virus, chlamydia, gonorrhea, syphilis, campylobacter, pityrosporum, trichophyton, aspergillus, acanthamoeba, entamoeba, giardia, strongyloides, basal cell carcinoma, squamous cell carcinoma, idiopathic thrombocytopenic purpura, cerebrovascular infarction, and intracranial hemorrhage.27–30
Pneumocystis carinii pneumonia once was the most common presentation of AIDS. It is typically of insidious onset, with features including dry cough, dyspnea, and a diffuse bilateral interstitial infiltrate evident on a chest roentgenogram. Typical multifocal fundus lesions have been described. They are yellow-white and have a characteristic pattern on fluorescein angiography (Fig. 10A, 10B, and 10C). Diagnosis is made by demonstrating the protozoon via sputum induction, bronchioalveolar lavage, and transbronchial or open-lung biopsies. Treatment modalities include trimethoprim-sulfamethoxazole (TMP-SMX).31
Kaposi's sarcoma is much more frequent in male homosexuals and bisexuals than in other patients with AIDS. Cutaneous lesions are usually red or violaceous, palpable, and nonblanching papules, nodules, or plaques, often appearing on the hard palate, nose, eyelid, and conjunctiva (Fig. 11). Visceral and lymph node involvement is common and often clinically silent. Biopsy specimens show proliferation of small, incompletely formed blood vessels lined by unusually large endothelial type cells, with extravasated red blood cells and infiltrates of spindle-shaped cells. Chemotherapy with etoposide, Vinca alkaloids, or interferon-α may be indicated in advanced cases.28
|
Mycobacterium avium-intracellulare (MAI), M. kansasii, and other atypical mycobacteria most commonly present as disseminated infections in patients with AIDS, with fever, sweats, chills, malaise, weight loss, and pulmonary and gastrointestinal symptoms. Signs of malabsorption, jaundice, skin lesions, and oral ulcers may be noted. Blood cultures, stool examination, and biopsy of various sites including lymph nodes, liver, gastrointestinal tract, skin and bone marrow may be useful for diagnosis by smear or culture. Antituberculosis therapy may improve symptoms, but such infections are generally regarded as incurable in those with AIDS. The fundus lesions of MAI consist of discrete yellow-white choroidal foci (Fig. 12A and 12B).32 Extrapulmonary M. tuberculosis is an indicator disease and is covered elsewhere in this chapter.
Cryptosporidium species and Isospora belli are intestinal protozoa causing severe diarrhea in the immunosuppressed. Among patients with AIDS, it is more common in homosexual males and children. Stool specimens and intestinal and other biopsies may yield the organisms for diagnosis. Disease is usually self-limited but may be life-threatening in the compromised patient. Therapy is mainly supportive. Spiramycin, α-difluoromethylornithine, and furazolidone have been used to treat cryptosporidiosis, and TMP-SMX for isosporiasis, all with limited success. Giardiasis and amoebic colitis are also seen in patients with AIDS.33
Progressive multifocal leukoencephalopathy is a chronic central demyelinating disease caused by the papovavirus JC (Jacob-Creutzfeldt virus). The disease may begin with subtle encephalopathic signs, later demonstrating various focal deficits. Visual loss is frequently reported. Computed tomography typically shows multiple hypodense nonenhancing lesions in white matter, and cerebrospinal fluid is usually normal or shows elevated protein. Diagnosis is made by brain biopsy. There is no effective therapy.25
Lymphocytic interstitial pneumonitis (LIP) occurs in approximately half of children with AIDS. Pulmonary lymphoid hyperplasia (PLH) is a nodular variant of LIP. The LIP/PLH complex is yet another AIDS-related chronic pulmonary disease presenting with diffuse bilateral interstitial infiltrates. Biopsy demonstrates either nodular peribronchiolar lymphoid aggregates, or diffuse alveolar and peribronchiolar lymphocytic and plasma cell infiltrates. Exacerbations may indicate superimposed infection. Corticosteroid therapy is controversial.30,31
CMV, herpes simplex and zoster, candidiasis, cryptococcosis, toxoplasmosis, and other AIDS-related infections are described in detail elsewhere in this chapter.
The ophthalmic findings associated with AIDS are reviewed in another chapter of this section. Approximately 80% of HIV-positive patients will have ocular manifestations during the course of their illness. Commonly encountered anterior segment manifestations include keratoconjunctivtis sicca, infectious keratitis, iritis, herpes-zoster ophthalmicus, Kaposi's sarcoma of the lid or conjunctiva, molluscum contagiosum and conjunctival microvasculopathy. Posterior segment manifestations include cytomegalovirus retinitis, VZV retinitis, toxoplasmic retinochoroiditis, infectious choroiditis, bacterial and fungal retinitis and the more recently reported chronic multifocal retinal infiltrates.32–39 Neuroophthalmic manifestations include papilledema, cranial nerve palsies, ocular motility disorders and visual field defects. They occur in 10% to 15% of patients with HIV infection.
Serologic diagnosis of HIV infection uses enzyme-linked immunosorbent assay (ELISA) kits for serum antibody detection. These assays are highly sensitive and may demonstrate false-positive results. Positive tests are therefore confirmed by repeat ELISA, followed by the Western blot test, which relies on the banding pattern of serum antibody to electrophoretically separated viral antigens.
Seroconversion usually occurs within 2 to 3 months, but may take much longer. Assay results will occasionally be read as indeterminate, indicating a reaction pattern that does not meet criteria for positivity, and retesting in several months is advised. Because of placental transfer of antibodies, a seropositive child younger than 15 months old must have other evidence of infection to support a diagnosis, such as clinical disease, positive HIV cultures, or HIV antigen testing. Serologic testing for HIV requires written informed patient consent in some locales, at least in part because of social stigmata associated with AIDS. Testing is now mandatory in the United States for blood donors, federal prisoners, military recruits and active-duty personnel, foreign-service officers, and immigrants to the United States.
In addition to HIV serodiagnosis, absolute T4 lymphocytopenia is the most useful laboratory finding related to HIV infection. A count of less than or equal to 400 cells/mm3 increases the risk of progression to AIDS.
Zidovudine (azidothymidine [AZT]) is a nucleoside analogue that inhibits viral reverse transcriptase. Zidovudine is virostatic, having no effect on latent virus. Taken orally, it has been shown to decrease symptoms, opportunistic infections, mortality rate, and HIV antigen values and to improve immunologic function in infected patients. The ability of HIV to undergo rapid antigenic variation of envelope glycoproteins, its low immunogenicity, and our incomplete understanding of what constitutes a protective immune response have contributed to the difficulty in developing an effective vaccine.
Several other antiretroviral agents known by their classification as nucleoside analogues, nonnucleoside analogues, or protease inhibitors have been introduced. Nucleoside analogues inhibit transcription of the HIV virus by blocking the enzyme reverse transcriptase, thereby inhibiting replication of the virus. Nucleoside analogues include Didanosine (ddI), Zalcitabine (ddC), Stavudine, (d4T) and Lamivudine (3TC). Combivir, a combination of AZT and 3TC, is a popular choice in initial HIV therapy. Drugs known as nonnucleoside analogues, nevirapine and delavirdine, may be used in combination with nucleoside analogues. Due to high levels of resistance to AZT monotherapy, various combinations usually consisting of three different drugs are typically employed. This new armamentarium of medications against the human immunodeficiency virus has dramatically lengthened life expectancy and improved quality of life.36
In 1996, the clinical introduction of the protease inhibitor (PI) class of antiretrovirals, promised a dramatic breakthrough in the ability to demonstrate a significant impact on the amount of detectable virus in both blood plasma and lymphoid tissue (LT), the principal site of HIV replication and storage. It has now become standard practice to initiate HAART (highly active antiretroviral therapy) with combinations of PIs and other antiretrovirals to more completely and durably suppress viral replication. Some practitioners wait to introduce the protease inhibitors into the cocktail of medications until later stages of immunosuppression. The most commonly used protease inhibitors are saquinavir, indinavir, and ritonavir.
EPSTEIN-BARR VIRUS
Epstein-barr virus (EBV) is a ubiquitous DNA virus that belongs to the human herpesvirus family. In early childhood the infection is usually subclinical; however in adolescence and early adulthood it is the principal cause of infectious mononucleosis.
By adulthood more than 90% of the population demonstrates antibody to the virus. EBV is often transmitted by intimate contact with asymptomatic carriers. Live virus has been found to persist in the oropharynx for up to 18 months after clinical recovery from the initial infection. Infectious mononucleosis has also occurred after blood transfusions and open heart surgery.
EBV infection is characterized by the classic triad of fever, sore throat and lymphadenopathy. Cervical adenopathy is present in 80% to 90% of patients. Splenomegaly occurs in 50% of patients. Other signs include hepatomegaly, jaundice, palatal petechiae, and rash. A wide spectrum of complications have been observed with EBV infection. These include anemia, thrombocytopenia, hepatitis, pericarditis, myocarditis, meningitis, encephalitis, optic neuritis, Guillain-Barré syndrome, and rarely, splenic rupture. Most patients recover spontaneously over a 2- to 3-week period, although rare fatalities have been reported.
Conjunctivitis is the most commonly reported of all ocular manifestations. Other manifestations include Sjögren's syndrome, conjunctival lymphocytic infiltrates,40 dacryoadenitis,41 keratitis, oculoglandular syndrome, uveitic, choroiditis, retinitis, acute posterior multifocal placoid pigment epitheliopathy (APMPPE), papillitis, and ophthalmoplegia. Even in cases of retinal involvement, EBV rarely if ever leads to permanent loss of vision. Resolution of the posterior segment inflammation usually leads to return of normal acuity.42,43
EBV infection may be related to neoplasia in several settings. This includes Burkitt's lymphoma in patients of African descent and nasopharyngeal carcinoma in Asians.
Diagnosis of EBV may be made clinically and with serologic demonstration of heterophil antibodies. Serum antibody titers to EBV capsid antigen can also be specifically tested. Treatment of EBV is largely supportive. Corticosteroids may be useful in the treatment of severe thrombocytopenia or hemolytic anemia, but are usually of limited value. Antiviral therapy such as acyclovir or interferon-α may be considered for slowly resolving EBV retinitis because both have been shown to inhibit EBV replication in vitro.
MUMPS
The mumps virus is an encapsulated RNA virus in the paramyxovirus family that causes acute parotitis in children and young adults. The virus is transmitted in saliva and respiratory secretions. Most cases of mumps occur in the winter and early spring. The primary clinical features are fever and nonsuppurative salivary gland inflammation. Orchitis is present in 20% to 30% of postpubescent males. Meningitis, meningoencephalitis, pancreatitis, oophoritis, myocarditis, and sensorineural hearing loss are less common complications of mumps infection.44
A nonspecific conjunctivitis is a relatively common finding in patients with mumps infection and is occasionally hemorrhagic. Dacryoadentitis, episcleritis, scleritis, keratitis, optic neuritis, and more recently reported acute posterior multifocal placoid pigment epitheliopathy45 and neuroretinitis46 after mumps.
The diagnosis of mumps can usually be made based on clinical findings. The virus can be cultured from saliva or spinal fluid, and seroconversion can be documented by a variety of assays. Efforts at preventing infection are primarily to avoid the complications of orchitis and encephalitis. Vaccination with live attenuated virus successfully produces immunity in approximately 90% of subjects. Since the licensing of the vaccine in 1967 there has been a more than 99% decline in the annual incidence of mumps in the United States.44 Prior to institution of the vaccine, epidemics of mumps occurred every 2 to 5 years. Mumps is now so rare that only 751 cases were reported to the CDC in 1996. Treatment of mumps is symptomatic and supportive with analgesics and antipyretics.
MEASLES
Measles is a highly contagious viral exanthem caused by an encapsulated single-stranded RNA virus in the paramyxovirus family. The illness is characterized by a prodromal period of malaise, with conjunctival and respiratory irritation followed by a maculopapular rash. Measles has a worldwide distribution. Its incidence has diminished in developed countries as a result of vaccination programs. Between 1990 and 1996, fewer than 1000 cases per year in the United States were reported to the CDC. However, measles still remains a serious cause of childhood illness, blindness, and mortality in developing countries.
Measles is transmitted by direct contact with infectious respiratory droplets. The attack rate exceeds 90% among susceptible persons. The prodromal symptoms develop 10 to 14 days after exposure and precede the rash by three to four days. Bright red spots with a bluish white center (Koplik's spots) appear on the buccal mucosa 1 to 2 days before the exanthem and are considered pathognomonic of measles. The rash consists of reddish, maculopapular lesions that first appear at the hairline and subsequently descend over the face, neck, and upper trunk, reaching the lower extremities on the third or fourth day.47
Pneumonia, laryngotracheitis, otitis media, mastoiditis, lymphadenitis, diarrhea, and keratoconjunctivtis are common complications of measles infection. Although rare, measles encephalitis and hemorrhagic thrombocytopenia lead to significant morbidity and mortality. Subacute sclerosing panencephalitis (SSPE) is believed to be caused by a chronic infection of the brain by the measles virus, leading to a slow and progressive degeneration of intellect and motor function that culminates in decorticate rigidity and death. Chorioretinitis is a common finding among patients with SSPE.48–50 Nystagmus, optic atrophy, papilledema, involuntary eye movements, and cortical blindness also occur with this condition.
Other ocular findings in measles include a nonspecific conjunctivitis with follicles or papillae and conjunctival hyperemia. An occasional Koplik's spot may be seen. In severe cases, punctate erosions of the bulbar conjunctiva are accompanied by a mucopurulent discharge. Subepithelial corneal infiltrates that stain with fluorescein may also appear transiently during the illness.51 Patients with poor nutritional status or vitamin A deficiency may develop corneal ulceration or perforation. Measles encephalitis is associated with optic neuritis, neuroretinitis,52 and extraocular muscle palsies.
A clinical diagnosis of measles can be made in patients with the characteristic prodrome and morbilliform rash. Laboratory confirmation is obtained by demonstrating seroconversion.
Treatment of patients with measles is supportive. Secondary bacterial infections and dehydration should be treated aggressively. The live attenuated virus vaccine gives a 98% conversion rate under ideal conditions. After immunization, fever and a mild rash may develop; rare cases of encephalitis and uveitis have occurred.53 No therapy is required for the conjunctivitis.
RUBELLA
Rubella (German measles) is a childhood exanthem caused by an encapsulated RNA virus of the togavirus group. The viral illness may be totally asymptomatic in adults or present with a mild self-limited fever, morbilliform rash, and lymphadenopathy. The most significant aspect of rubella infection is in its effect on the fetus. Prenatal infection may result in miscarriage, stillbirth or the congenital rubella syndrome.
Since 1969, the year of rubella vaccine licensure, the incidence of rubella infection and congenital rubella have declined 99% in the United States. Most cases occur in the spring, the highest incidence being among children. Patients are most contagious in the week prior to the eruption of the rash and transmit the virus through respiratory droplets. Infants with congenital rubella shed large quantities of virus in their body fluids for months and may retain viable virus in the lens for years after the initial infection.54
Despite immunization programs, 10% to 20% of young adults remain susceptible to rubella infection and limited local outbreaks continue to occur in settings such as schools and military bases where groups of susceptible persons are in close contact.
Typically there are no prodromal symptoms of rubella infection in children: however, adults may experience malaise, fever, and anorexia for several days before the rash erupts. Ocular features generally include conjunctivitis and epithelial keratitis. Lymphadenopathy occurs most commonly in the posterior auricular, posterior cervical, and suboccipital lymph nodes; generalized adenopathy and splenomegaly occasionally are seen. The exanthem of rubella begins on the forehead and face and spreads downward to the trunk and limbs. The lesions are discrete and maculopapular but may coalesce to form a diffuse erythema. Petechial lesions may erupt on the soft palate (Forschheimer spots). In young women, a self-limited arthritis involving the wrists, fingers, and knees may accompany the rash and occasionally persists after the other manifestations of rubella have disappeared.55
Rubella infections that occur early in gestation are associated with the greatest risk of fetal damage, however, infection in the third trimester may still cause damage. Maternal infection in the first 2 months of pregnancy results in a 40% to 60% chance of multiple congenital anomalies or fetal death. Congenital heart disease, cataracts, and deafness are the classic triad of the congenital rubella syndrome; however, there are many other commonly recognized complications of prenatal rubella infection (Fig. 13). Encephalitis, microcephaly, mental retardation, intrauterine growth retardation, thrombocytopenic purpura, hepatosplenomegaly, obstructive jaundice, interstitial pneumonitis, myocarditis, and radiolucent bone lesions are all possible sequelae of congenital rubella infection.54 The classic salt-and-pepper retinopathy occurs less commonly (Fig. 14), but may be noted to show progression. Other ocular findings include congenital cataracts, microphthalmia and glaucoma. Ocular disease and hearing loss frequently occur together, and glaucoma is frequently associated with microphthalmos.56
|
|
The devastating fetal damage caused by maternal rubella infections can only be prevented through rigorous immunization programs. All susceptible women of childbearing age should be vaccinated 3 months before a planned pregnancy or in the postpartum period. As a result of immunization programs there have been no major outbreaks of rubella in the last 35 years.
Postnatal rubella infection may go undetected because of its mild and nonspecific symptomatology. The diagnosis can be made by culturing virus from the throat or by demonstrating rising antibody titers to rubella specific IgG. When suggestive birth defects are present, the diagnosis of congenital rubella requires either viral isolation from the throat, urine, or other body secretions or serologic evidence of infection.